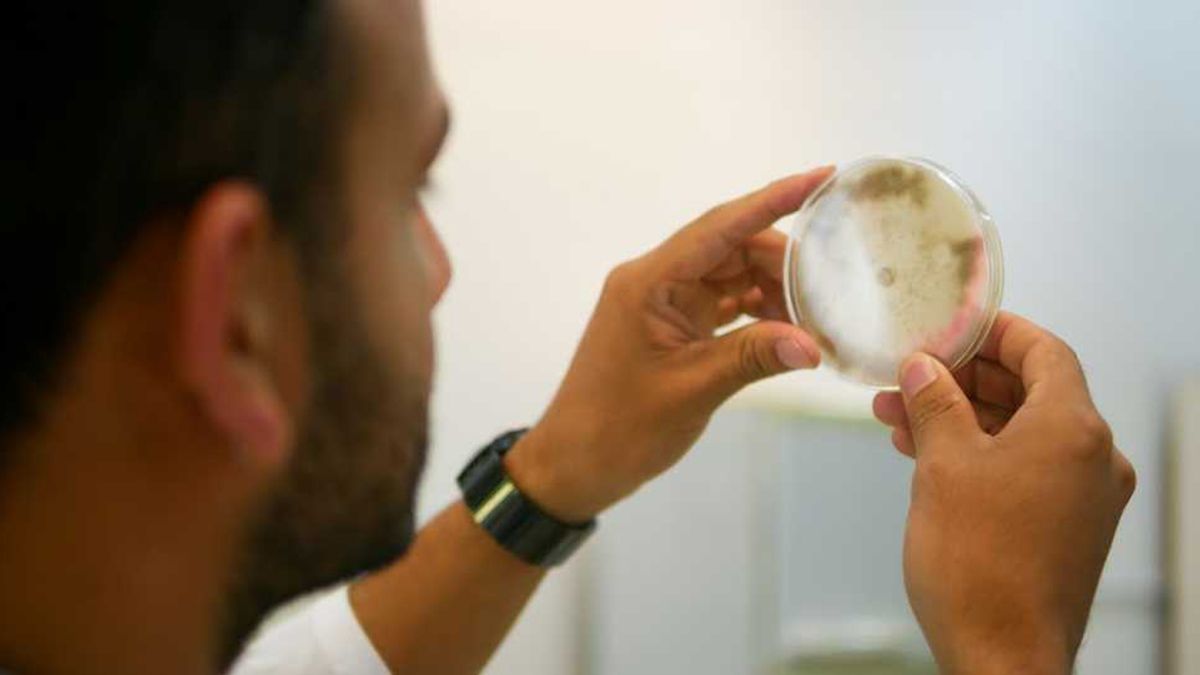

Johan Rodríguez Melo (30) terminó el Doctorado en Ciencias Biológicas de la Universidad Nacional de Río Cuarto durante la pandemia y ahora integra una empresa de reciente creación que ganó el Premio Santander X Global 2023, del que participaron dos mil propuestas de ocho países.
Desarrollaron ARN estabilizados de doble cadena como precursores exógenos para la defensa de cultivos específicos frente a patógenos tales como hongos, virus e insectos, lo cual permite el reemplazo de agroquímicos para el control de pestes.
Con esta innovación, se convirtieron en uno de los seis ganadores del premio al emprendimiento universitario, competencia global en cuya final hubo una veintena de proyectos.
Hace un año armaron Apolo BioTech, una compañía nueva, radicada en Santa Fe, que desarrolla tecnologías basadas en ácido ribonucleico (ARN) para aumentar la productividad sin dañar el medioambiente. Actualmente, se han focalizado en hongos patógenos y virus de diferentes cultivos de interés agrícola.
“La novedad de nuestro trabajo radica en la utilización del ARN como molécula exógena para brindarle a la planta las herramientas para que pueda defenderse”, dice Rodríguez Melo.
“Esta tecnología busca que mediante ARN exógenos, es decir, aplicados al igual que cualquier otro producto para el agro, la planta adquiera la información que necesita para defenderse contra patógenos que las atacan”. “Es algo muy parecido a lo que hacen las vacunas en los humanos”. “Se trata de una tecnología disruptiva, respetuosa del ambiente y de la salud de las personas. Por eso el ARN emerge como una molécula central de la biotecnología del siglo XXI, tanto en la industria farmacéutica como en el agro”, agrega al explicar en qué consisten estas tecnologías y cómo se las usa para aumentar la productividad.
Este científico oriundo de Colombia viene trabajando en la búsqueda de una solución inocua y ecoamigable que reemplace a los agroquímicos sintéticos, que se usan para proteger los cultivos de las plagas y mejorar el rendimiento a costa de la degradación de la tierra, la contaminación del aire, la resistencia emergente de las especies de hongos a los fungicidas. “Una vacuna contra los patógenos, sin peligros para el medioambiente”, según sus palabras.
Rodríguez Melo llegó desde la colombiana Universidad de Quindío a la UNRC primero en el marco de un intercambio estudiantil de grado y luego para doctorarse en Ciencias Biológicas.
“Interconexiones entre las vías moleculares que median la simbiosis fijadora de nitrógeno y las reacciones de defensa contra fitopatógenos en Arachis hipogaea L (Maní)” se titula la tesis doctoral que hizo en la UNRC.
Ahora, con su equipo se destacó en el marco de una gran variedad de ideas innovadoras de “startups” y “scaleups” que se presentaron en esta competición internacional organizada por el Banco Santander, con eje en la invención, el emprendimiento y la educación superior. En esta edición de “Santander X Global Award 2023” participaron emprendedores universitarios de Argentina, Brasil, Chile, España, México, Portugal, Reino Unido y Uruguay.
Los premios se entregaron en Valencia, el marco del V Encuentro Internacional de Rectores Universia. Los proyectos ganadores recibieron un total de 60.000 euros y acceso a “SantanderX 100”, la comunidad creada por la entidad financiera para reunir a las más destacadas startups y scaleups.
Apolo BioTech diseña ARN bicatenarios estabilizados como precursores exógenos para defensas específicas de cultivos contra patógenos (hongos, virus e insectos). Es una tecnología que permite la sustitución de agroquímicos sintéticos para el control de plagas. Las moléculas de ARN son orgánicas, inocuas y altamente específicas y ofrecen soluciones amigables con el medioambiente y la salud humana. Además, los ARN exógenos están libres de organismo genéticamente modificados y pueden modular el desarrollo de las plantas, la acumulación de metabolitos o la respuesta al estrés ambiental.
El ARN es la molécula intermediaria entre el ADN y las proteínas. El mejoramiento genético, clásico o transgénico, implica cambios en el ADN. Sin embargo, cuando un ARN exógeno ingresa a la célula, puede traducirse en proteína.
Con ARN exógenos pueden adaptar la respuesta del cultivo al ambiente, o inducir la producción de un metabolito de interés. En plantas sensoras de las hormonas auxinas –que participan durante todo el ciclo de vida de las plantas, las ayudan en su crecimiento y desarrollo-, al aplicar al ARN APOLO -que da nombre a esta nueva empresa-, logran modular el balance hormonal y modificar el comportamiento de la planta. Conociendo los genomas, apuntan a diseñar soluciones específicas que ataquen al patógeno sin perjudicar a los cultivos, el ambiente y la salud de productores y consumidores.
Una promisora carrera
“Me doctoré en diciembre del 2020, soy un doctor de la pandemia”, comenta Rodríguez Melo, al tiempo que agrega: “Soy licenciado en Biología y Educación Ambiental de la Universidad del Quindío, Colombia”. Y sigue: “En Apolo Biotech he estado participando desde su creación. El director de mi posdoctorado, el doctor Federico Ariel, me contó sobre la idea de participar en lo que sería una startup de agrobiotecnología para aplicar todo lo que sabíamos sobre ARN en la protección de cultivos de interés agrícola y sin pensarlo dos veces acepté y me sumé al equipo de I+D”.
- ¿Desarrollan tecnologías basadas en ácido ribonucleico?
- Es una startup radicada en el Parque Tecnológico del Litoral Centro (PTLC), usamos tecnologías basadas en ARN exógenos para proteger plantas de interés agrícola contra diferentes tipos de patógenos. Con esta tecnología disruptiva buscamos reducir considerablemente el uso de productos químicos sintéticos en la producción agrícola y, por qué no, reemplazarlos totalmente en un futuro no muy lejano.
- ¿Qué rol cumple usted en la empresa?
- Actualmente soy CTO –director de tecnología-, la persona encargada de liderar el equipo de I+D junto con el doctor Federico Ariel; diseñamos y probamos las soluciones alternativas basadas en ARN contra los diferentes patógenos.
- ¿Cómo se relaciona su trabajo con la formación doctoral que recibió en la UNRC?
- Están totalmente relacionados. Durante mi formación doctoral en la UNRC estuve trabajando con microorganismos benéficos y patógenos del cultivo de maní, con el doctor Fernando Ibáñez y la doctora Laura Tonelli, de la Facultad de Ciencias Exactas. Y accedí a diferentes cursos orientados a la interacción planta-microorganismo. Muchos de estos conocimientos hoy en día son aplicados en mi carrera científica.
- ¿En qué consisten estas tecnologías y cómo se las usa para aumentar la productividad?
- Esta tecnología busca que mediante ARN exógenos, es decir, aplicados al igual que cualquier otro producto para el agro, la planta adquiera la información que necesita para defenderse contra patógenos que las atacan. Es algo muy parecido a lo que hacen las vacunas en los humanos. Se trata de una tecnología disruptiva, respetuosa del ambiente y de la salud de las personas. Por eso el ARN emerge como una molécula central de la biotecnología del siglo XXI, tanto en la industria farmacéutica como en el agro.
- ¿A qué tipo de producción se aplica?
- Actualmente, estamos focalizados en la protección de cultivos intensivos, como el tomate, por ejemplo, pero exploramos nuevos horizontes con cultivos extensivos como el maní. También en poscosecha, para proteger frutas y verduras de patógenos durante el traslado y almacenamiento.
- ¿En qué consiste la presentación que les valió ganar el premio?
- Para llegar a participar de este premio, primero tomamos parte del concurso Santander Argentina Awards, en el cual quedamos en segundo lugar en el año 2022. Y fue gracias a esto que pudimos ir a la competencia global, en la que quedamos seleccionados como finalistas, y competimos junto con 20 startups y scaleups en el V Encuentro Internacional de Rectores Universia. Allí se presentó la propuesta de Apolo Biotech centrada en utilizar ARN para ayudar a las plantas a defenderse de patógenos y reducir la dependencia de los pesticidas sintéticos.
- ¿Qué es lo novedoso del trabajo premiado?
- La novedad de nuestro trabajo radica en la utilización del ARN como molécula exógena para brindarle a la planta las herramientas para que pueda defenderse. Es disruptiva en el sentido de que en realidad es información lo que le damos a la planta. Una vez aceptada esa información la planta la procesa y puede empezar a generar sus propias defensas contra los patógenos.
- ¿Qué participación tuvieron las universidades de Buenos Aires y del Litoral?
- En el equipo de investigación de Apolo Biotech participamos investigadores asociados de diferentes centros de investigación que están vinculados con estas tres universidades: la UBA, la UNL y en mi caso también la UNRC, por mi formación académica. El Premio busca visibilizar cómo el conocimiento científico generado en las universidades puede ser transformado en tecnología de vanguardia.
- ¿Es una invención? ¿Lo han patentado?
- Tenemos un pipeline de desarrollos bastante amplio, actualmente focalizado en hongos patógenos y virus de diferentes cultivos de interés agrícola. El mecanismo natural mediante el cual se generan las defensas en las plantas por ARN es algo que se estudia hace varios años, y nosotros replicamos ese mecanismo con fines tecnológicos. Además, contamos con tecnología propietaria que nos permite entregar esa información a la planta de manera eficaz y duradera. Actualmente, estamos trabajando en el proceso de protección de la tecnología y patentamiento.